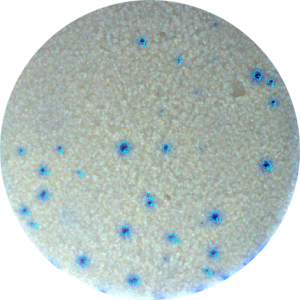
Application Elispot in 384 well microfilter plates

Elispot
Application
Elispot - Enzymatic single color

Blue, red, green or silver substrat Elispot.
Detection of antibodies. Enzyme-conjugated and precipitating substrate.
"The enzyme-linked immune absorbent spot (ELISpot) is a type of assay that focuses on quantitatively measuring the frequency of cytokine secretion for a single cell."
[https://en.wikipedia.org/wiki/ELISpot]
Why Elispot?
The cytokine Elispot assay is designed to enumerate cytokine secreting cells in single cell suspensions of lymphoid tissue, CNS tissue, bone marrow or preparations of peripheral blood mononuclear cells (PBMC).
The assay has the advantage of detecting only activated/memory T cells and the cytokine release can be detected at the single cell level, allowing direct determination of T cell frequencies.
The ELISPOT assay is an effective tool to enumerate antigen-specific T cells in the circulation of immunized humans and animals at much lower frequencies than possible with other currently available methods.
The ELISPOT assay has proven to be a sensitive and unique system to follow disease progression in human individuals or animals. Several studies have indicated that alterations in the frequency of cytokine pc in different compartments of the body adequately reflect changes in immune function.
The ELISPOT assay may be used to determine effects of drugs, chemicals or other compounds on cytokine secretion in vitro, thereby providing data on their putative modulatory effects on immune function in vivo
The ELISPOT assay is currently being used increasingly for the quantitative assessment of peptide reactive T lymphocytes from PBMC in infectious disease (3, 9) or in the course of vaccination trials aimed at the induction of tumor-specific T cells in patients with cancer.
Elispot may be used for Diagnosis of genetic defects,Allergic diseases,Autoimmune diseases,Transplantation,Cancer research,Acute inflammation,Acute infectious diseases and septic shock.

EAZYREADER® 7000
World's first 100 % scalable Elispot/Plaque Reader that may be upgraded on-site to a Single Cell/PBMC counter.

BIOREADER® 7000 -F-z-i
Versatile, Inverted high resolution Zoom Fluoro/VIS reader, micro + macro mode with innovative power LED fluoro excitation

BIOREADER® 7000 -F
Fluoro Elispot/Plaque + Enzymatic Readers for 96 wells with innovative power LED fluoro excitation.

BIOREADER® 7000 -V
For non-fluoro applications in 384 well to 6 well plates and Petri dishes.

BIOREADER® 7000 -E
Our Bioreader® counts 100% of the filter area! No losses due to the exclusion of the outer border/filter region.

BIOCOUNT® 7000
World's first Reader for 8-well strips
Application
Elispot - Enzymatic dual color

Blue and red Elispot substrate (mixed color violet)
Dual cytokine secretion.

EAZYREADER® 7000
World's first 100 % scalable Elispot/Plaque Reader that may be upgraded on-site to a Single Cell/PBMC counter.

BIOREADER® 7000 -F-z-i
Versatile, Inverted high resolution Zoom Fluoro/VIS reader, micro + macro mode with innovative power LED fluoro excitation

BIOREADER® 7000 -F
Fluoro Elispot/Plaque + Enzymatic Readers for 96 wells with innovative power LED fluoro excitation.

BIOREADER® 7000 -V
For non-fluoro applications in 384 well to 6 well plates and Petri dishes.

BIOREADER® 7000 -E
Our Bioreader® counts 100% of the filter area! No losses due to the exclusion of the outer border/filter region.
Application
Elispot in 384 well microfilter plates
Small volume, higher throughput.

EAZYREADER® 7000
World's first 100 % scalable Elispot/Plaque Reader that may be upgraded on-site to a Single Cell/PBMC counter.

BIOREADER® 7000 -F-z-i
Versatile, Inverted high resolution Zoom Fluoro/VIS reader, micro + macro mode with innovative power LED fluoro excitation

BIOREADER® 7000 -F
Fluoro Elispot/Plaque + Enzymatic Readers for 96 wells with innovative power LED fluoro excitation.

BIOREADER® 7000 -V
For non-fluoro applications in 384 well to 6 well plates and Petri dishes.

BIOREADER® 7000 -E
Our Bioreader® counts 100% of the filter area! No losses due to the exclusion of the outer border/filter region.




